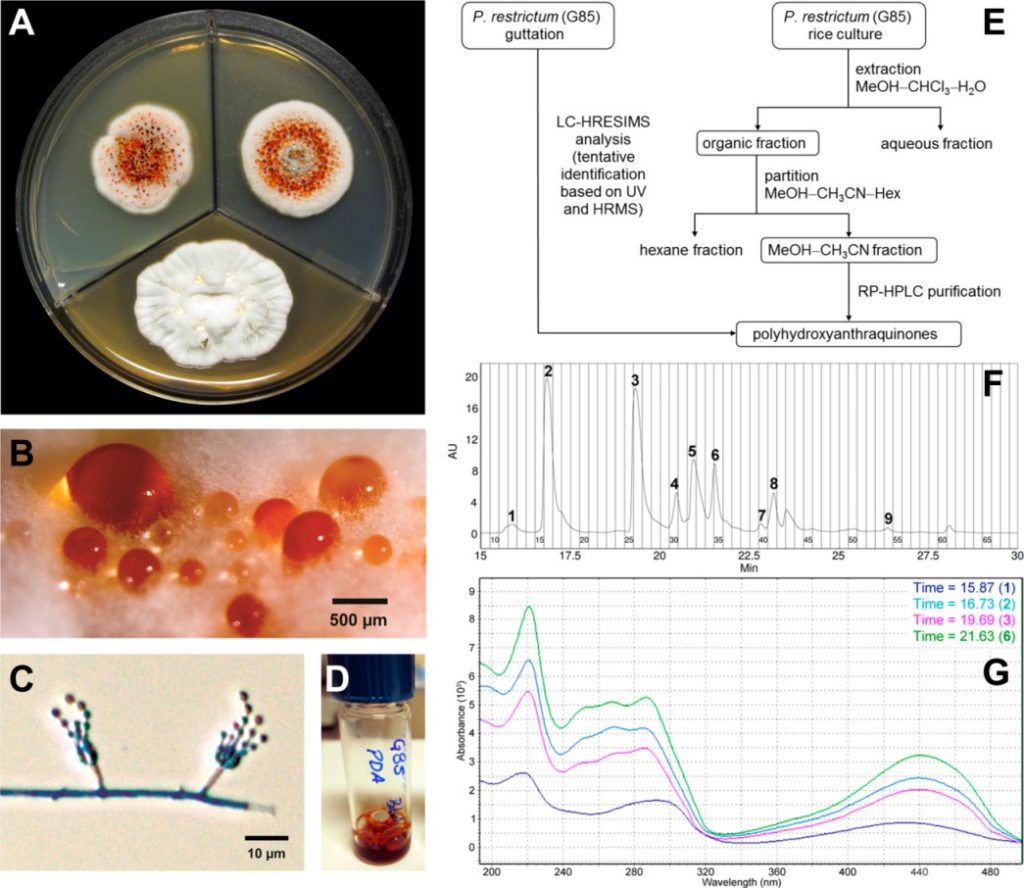

The Medicinal Chemistry Collaborative and Lloyd Honors College Host Underground Railroad Tree Exhibit in Downtown Greensboro
This spring, the Medicinal Chemistry Collaborative and Lloyd International Honors College have embarked on an exploration that transcends disciplinary boundaries. Students, faculty, and staff at UNC Greensboro have come together with research and creative activity inspired by a single 300-year-old tulip poplar tree in the Guilford Forest. The project coincides… Continue reading…